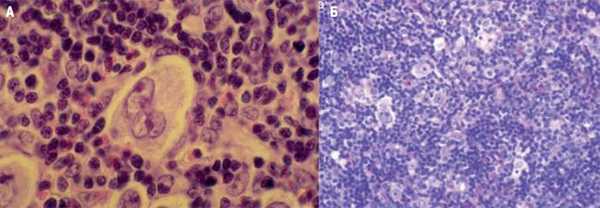
LX_ris_3_st_1.jpg

Синдром Ходжкина (Hodgkin) - синонимы, авторы, клиника
Добавил пользователь Евгений Кузнецов Обновлено: 08.01.2026
Лимфогранулематоз - злокачественная гиперплазия лимфоидной ткани, характерным признаком которой является образование гранулем с клетками Березовского-Штернберга. Для лимфогранулематоза специфично увеличение различных групп лимфатических узлов (чаще нижнечелюстных, надключичных, медиастинальных), увеличение селезенки, субфебрилитет, общая слабость, похудание. С целью верификации диагноза осуществляется биопсия лимфоузлов, диагностические операции (торакоскопия, лапароскопия), рентгенография грудной клетки, УЗИ, КТ, биопсия костного мозга. В лечебных целях при лимфогранулематозе проводится полихимиотерапия, облучение пораженных лимфоузлов, спленэктомия.



Общие сведения
Лимфогранулематоз (ЛГМ) - лимфопролиферативное заболевание, протекающее с образованием специфических полиморфно-клеточных гранулем в пораженных органах (лимфоузлах, селезенке и др.). По имени автора, впервые описавшего признаки заболевания и предложившего выделить его в самостоятельную форму, лимфогранулематоз также называют болезнью Ходжкина, или ходжкинской лимфомой. Средний показатель заболеваемости лимфогранулематозом составляет 2,2 случая на 100 тыс. населения. Среди заболевших преобладают молодые люди в возрасте 20-30 лет; второй пик заболеваемости приходится на возраст старше 60 лет. У мужчин болезнь Ходжкина развивается в 1,5-2 раза чаще, чем у женщин. В структуре гемобластозов лимфогранулематозу отводится втрое место по частоте возникновения после лейкемии.

Причины лимфогранулематоза
Этиология лимфогранулематоза до настоящего времени не выяснена. На сегодняшний день в числе основных рассматриваются вирусная, наследственная и иммунная теории генеза болезни Ходжкина, однако ни одна из них не может считаться исчерпывающей и общепризнанной. В пользу возможного вирусного происхождения лимфогранулематоза свидетельствует его частая корреляция с перенесенным инфекционным мононуклеозом и наличием антител к вирусу Эпштейна-Барр. По меньшей мере, в 20% исследуемых клеток Березовского-Штернберга обнаруживается генетический материал вируса Эпштейна-Барр, обладающего иммуносупрессивными свойствами. Также не исключается этиологическое влияние ретровирусов, в т. ч. ВИЧ.
На роль наследственных факторов указывает встречаемость семейной формы лимфогранулематоза и идентификация определенных генетических маркеров данной патологии. Согласно иммунологической теории, имеется вероятность трансплацентарного переноса материнских лимфоцитов в организм плода с последующим развитием иммунопатологической реакции. Не исключается этиологическое значение мутагенных факторов - токсических веществ, ионизирующего излучения, лекарственных препаратов и других в провоцировании лимфогранулематоза.
Предполагается, что развитие лимфогранулематоза становится возможным в условиях Т-клеточного иммунодефицита, о чем свидетельствует снижение всех звеньев клеточного иммунитета, нарушение соотношения Т-хелперов и Т-супрессоров. Главным морфологическим признаком злокачественной пролиферации при лимфогранулематозе (в отличие от неходжкинских лимфом и лимфолейкоза) служит присутствие в лимфатической ткани гигантских многоядерных клеток, получивших название клеток Березовского-Рид-Штернберга и их предстадий - одноядерных клеток Ходжкина. Кроме них опухолевый субстрат содержит поликлональные Т-лимфоциты, тканевые гистиоциты, плазматические клетки и эозинофилы. При лимфогранулематозе опухоль развивается уницентрически - из одного очага, чаще в шейных, надключичных, медиастинальных лимфатических узлах. Однако возможность последующего метастазирования обусловливает возникновение характерных изменений в легких, ЖКТ, почках, костном мозге.
Классификация лимфогранулематоза
В гематологии различают изолированную (локальную) форму лимфогранулематоза, при которой поражается одна группа лимфоузлов, и генерализованную - со злокачественной пролиферацией в селезенке, печени, желудке, легких, коже. По локализационному признаку выделяется периферическая, медиастинальная, легочная, абдоминальная, желудочно-кишечная, кожная, костная, нервная формы болезни Ходжкина.
В зависимости от скорости развития патологического процесса лимфогранулематоз может иметь острое течение (несколько месяцев от начальной до терминальной стадии) и хроническое течение (затяжное, многолетнее с чередованием циклов обострений и ремиссий).
На основании морфологического исследования опухоли и количественного соотношения различных клеточных элементов выделяют 4 гистологические формы лимфогранулематоза:
- лимфогистиоцитарную, или лимфоидное преобладание
- нодулярно-склеротическую, или нодулярный склероз
- смешанно-клеточную
- лимфоидное истощение
В основу клинической классификации лимфогранулематоза положен критерий распространенности опухолевого процесса; в соответствии с ним развитие болезни Ходжкина проходит 4 стадии:
I стадия (локальная) - поражена одна группа лимфоузлов (I) либо один экстралимфатический орган (IE).
II стадия (регионарная) - поражены две или более группы лимфатических узлов, расположенных с одной стороны диафрагмы (II) либо один экстралимфатический орган и его регионарные лимфоузлы (IIE).
III стадия (генерализованная) - пораженные лимфоузлы расположены с обеих сторон диафрагмы (III). Дополнительно может поражаться один экстралимфатический орган (IIIE), селезенка (IIIS) либо они вместе (IIIE + IIIS).
IV стадия (диссеминированная) - поражение затрагивает один или несколько экстралимфатических органов (легкие, плевру, костный мозг, печень, почки, ЖКТ и др.) с одновременным поражением лимфоузлов или без него.
Для обозначения наличия или отсутствия общих симптомов лимфогранулематоза на протяжении последних 6 месяцев (лихорадки, ночной потливости, похудания) к цифре, обозначающей стадию болезни, добавляются буквы А или В соответственно.
Симптомы лимфогранулематоза
К числу характерных для лимфогранулематоза симптомокомплексов относятся интоксикация, увеличение лимфатических узлов и возникновение экстранодальных очагов. Часто заболевание начинается с неспецифических симптомов - периодической лихорадки с температурными пиками до 39°С, ночной потливости, слабости, похудания, кожного зуда.
Нередко первым «вестником» лимфогранулематоза служит увеличение доступных для пальпации лимфоузлов, которые больные обнаруживают у себя самостоятельно. Чаще это шейные, надключичные лимфатические узлы; реже - подмышечные, бедренные, паховые. Периферические лимфоузлы плотные, безболезненные, подвижные, не спаяны между собой, с кожей и окружающими тканями; обычно тянутся в виде цепочки.
У 15-20% пациентов лимфогранулематоз дебютирует с увеличения лимфоузлов средостения. При поражении медиастинальных лимфоузлов первыми клиническими признаками болезни Ходжкина могут служить дисфагия, сухой кашель, одышка, синдром ВПВ. Если опухолевый процесс затрагивает забрюшинные и мезентериальные лимфоузлы, возникают абдоминальные боли, отеки нижних конечностей.
Неходжкинские лимфомы ( Лимфосаркома )
Неходжкинские лимфомы - опухолевые заболевания лимфатической системы, представленные злокачественными B- и T-клеточными лимфомами. Первичный очаг может возникать в лимфатических узлах либо других органах и в дальнейшем метастазировать лимфогенным или гематогенным путем. Клиника лимфом характеризуется лимфаденопатией, симптомами поражения того или иного органа, лихорадочно-интоксикационным синдромом. Диагностика основывается на клинико-рентгенологических данных, результатах исследования гемограммы, биоптата лимфоузлов и костного мозга. Противоопухолевое лечение включает курсы полихимиотерапии и лучевой терапии.
МКБ-10



Неходжкинские лимфомы (НХЛ, лимфосаркомы) - различные по морфологии, клиническим признакам и течению злокачественные лимфопролиферативные опухоли, отличные по своим характеристикам от лимфомы Ходжкина (лимфогранулематоза). В зависимости от места возникновения первичного очага гемобластозы делятся на лейкозы (опухолевые поражения костного мозга) и лимфомы (опухоли лимфоидной ткани с первичной внекостномозговой локализацией). На основании отличительных морфологических признаков лимфомы, в свою очередь, подразделяются на ходжкинские и неходжкинские; к числу последних в гематологии относят В- и Т-клеточные лимфомы. Неходжкинские лимфомы встречаются во всех возрастных группах, однако более половины случаев лимфосарком диагностируется у лиц старше 60 лет. Средний показатель заболеваемости среди мужчин составляет 2-7 случая, среди женщин - 1-5 случаев на 100 000 населения. В течение последних лет прослеживается тенденция к прогрессирующему увеличению заболеваемости.

Причины
Этиология лимфосарком достоверно неизвестна. Более того, причины лимфом различных гистологических типов и локализаций существенно варьируются. В настоящее время правильнее говорить о факторах риска, повышающих вероятность развития лимфомы, которые на данный момент хорошо изучены. Влияние одних этиофакторов выражено значительно, вклад других в этиологию лимфом весьма несущественен. К такого рода неблагоприятным предпосылкам относятся:
- Инфекции. Наибольшим цитопатогенным эффектом на лимфоидные клетки обладает вирус иммунодефицита человека (ВИЧ), гепатита С, Т-лимфотропный вирус 1 типа. Доказана связь инфицирования вирусом Эпштейна-Барр с развитием лимфомы Беркитта. Известно, что инфекция Helicobacter pylori, ассоциированная с язвенной болезнью желудка, может вызывать развитие лимфомы той же локализации.
- Дефекты иммунитета. Риск возникновения лимфом повышается при врожденных и приобретенных иммунодефицитах (СПИДе, синдроме Вискотта-Олдрича, Луи-Бар, Х-сцепленном лимфопролиферативном синдроме и др.). У пациентов, получающих иммуносупрессивную терапию по поводу трансплантации костного мозга или органов, вероятность развития НХЛ увеличивается в 30-50 раз.
- Сопутствующие заболевания. Повышенный риск заболеваемости НХЛ отмечается среди пациентов с ревматоидным артритом, красной волчанкой, что может быть объяснено как иммунными нарушениями, так и использованием иммуносупрессивных препаратов для лечения данных состояний. Лимфома щитовидной железы обычно развивается на фоне аутоиммунного тиреоидита.
- Токсическое воздействие. Прослеживается причинно-следственная связь между лимфосаркомами и предшествующим контактом с химическими канцерогенами (бензолом, инсектицидами, гербицидами), УФ-излучением, проведением лучевой терапии по поводу онкологического заболевания. Прямое цитопатическое действие оказывают цитостатические препараты, применяемые для химиотерапии.
Патогенез
Патологический лимфогенез инициируется тем или иным онкогенным событием, вызывающим нарушение нормального клеточного цикла. В этом могут быть задействованы два механизма - активация онкогенов либо подавление опухолевых супрессоров (антионкогенов). Опухолевый клон при НХЛ в 90% случаев формируется из В-лимфоцитов, крайне редко - из Т-лимфоцитов, NK- клеток или недифференцированных клеток.
Для различных типов лимфом характерны определенные хромосомные транслокации, которые приводят к подавлению апоптоза, утрате контроля над пролиферацией и дифференцировкой лимфоцитов на любом этапе. Это сопровождается появлением клона бластных клеток в лимфатических органах. Лимфоузлы (периферические, медиастинальные, мезентериальные и др.) увеличиваются в размерах и могут нарушать функцию близлежащих органов. При инфильтрации костного мозга развивается цитопения. Разрастание и метастазирование опухолевой массы сопровождается кахексией.
Классификация
Лимфосаркомы, первично развивающиеся в лимфоузлах называются нодальными, в других органах (небной и глоточных миндалинах, слюнных железах, желудке, селезенке, кишечнике, головном мозге, легких, коже, щитовидной железе и др.) - экстранодальными. По структуре опухолевой ткани НХЛ делятся на фолликулярные (нодулярные) и диффузные. По темпам прогрессирования лимфомы классифицируются на индолентные (с медленным, относительно благоприятным течением), агрессивные и высоко агрессивные (с бурным развитием и генерализацией). При отсутствии лечения больные с индолентными лимфомами живут в среднем 7 - 10 лет, с агрессивными - от нескольких месяцев до 1,5-2 лет.
Современная классификация насчитывает свыше 30 различных видов лимфосарком. Большая часть опухолей (85%) происходит из В-лимфоцитов (В-клеточные лимфомы), остальные из Т-лимфоцитов (Т-клеточные лимфомы). Внутри этих групп существуют различные подтипы неходжкинских лимфом. Группа В-клеточных опухолей включает:
- диффузную В-крупноклеточную лимфому - самый распространенный гистологический тип лимфосарком (31%). Характеризуется агрессивным ростом, несмотря на это почти в половине случаев поддается полному излечению.
- фолликулярную лимфому - ее частота составляет 22% от числа НХЛ. Течение индолентное, однако возможна трансформация в агрессивную диффузную лимфому. Прогноз 5-летней выживаемости - 60-70%.
- мелкоклеточную лимфоцитарную лимфомуи хронический лимфоцитарный лейкоз - близкие типы НХЛ, на долю которых приходится 7% от их числа. Течение медленное, но плохо поддающееся терапии. Прогноз вариабелен: в одних случаях лимфосаркома развивается в течение 10 лет, в других - на определенном этапе превращается в быстрорастущую лимфому.
- лимфому из мантийных клеток- в структуре НХЛ составляет 6%. Пятилетний рубеж выживаемости преодолевает лишь 20% больных.
- В-клеточные лимфомы из клеток маргинальной зоны - делятся на экстранодальные (могут развиваться в желудке, щитовидной, слюнных, молочных железах), нодальные (развиваются в лимфоузлах), селезеночную (с локализацией в селезенке). Отличаются медленным локальным ростом; на ранних стадиях хорошо поддаются излечению.
- В-клеточную медиастинальную лимфому - встречается редко (в 2% случаев), однако в отличие от других типов поражает преимущественно молодых женщин 30-40 лет. В связи с быстрым ростом вызывает компрессию органов средостения; излечивается в 50% случаев.
- макроглобулинемию Вальденстрема (лимфоплазмоцитарную лимфому) - диагностируется у 1% больных с НХЛ. Характеризуется гиперпродукцией IgM опухолевыми клетками, что приводит к повышению вязкости крови, сосудистым тромбозам, разрывам капилляров. Может иметь как относительно доброкачественное (с выживаемостью до 20 лет), так и скоротечное развитие (с гибелью пациента в течение 1-2 лет).
- волосатоклеточный лейкоз- очень редкий тип лимфомы, встречающийся у лиц пожилого возраста. Течение опухоли медленное, не всегда требующее лечения.
- лимфому Беркитта - на ее долю приходится около 2% НХЛ. В 90% случаев опухоль поражает молодых мужчин до 30 лет. Рост лимфомы Беркитта агрессивный; интенсивная химиотерапия позволяет добиться излечение половины больных.
- лимфому центральной нервной системы - первичное поражение ЦНС может затрагивать головной или спинной мозг. Чаще ассоциируется с ВИЧ-инфекцией. Пятилетняя выживаемость составляет 30%.
Неходжкинские лимфомы Т-клеточного происхождения представлены:
- Т-лимфобластной лимфомой или лейкозом из клеток-предшественников - встречается с частотой 2%. Различаются между собой количеством бластных клеток в костном мозге: при 25% - как лейкоз. Диагностируется преимущественно у молодых людей, средний возраст заболевших - 25 лет. Худший прогноз имеет Т-лимфобластный лейкоз, показатель излечения при котором не превышает 20%.
- периферическими Т-клеточными лимфомами, включающими кожную лимфому (синдром Сезари, грибовидный микоз), ангиоиммунобластную лимфому, экстранодальную лимфому из естественных киллеров, лимфому с энтеропатией, панникулитоподобную лимфому подкожной клетчатки, крупноклеточную анапластическую лимфому. Течение большей части Т-клеточных лимфом быстрое, а исход неблагоприятный.

Симптомы
Варианты клинических проявлений НХЛ сильно варьируются в зависимости от локализации первичного очага, распространенности опухолевого процесса, гистологического типа опухоли и пр. Все проявления лимфосарком укладываются в три синдрома: лимфаденопатии, лихорадки и интоксикации, экстранодального поражения. В большинстве случаев первым признаком НХЛ служит увеличение периферических лимфоузлов. Вначале они остаются эластичными и подвижными, позднее сливаются в обширные конгломераты. Одновременно могут поражаться лимфоузлы одной или многих областей. При образовании свищевых ходов необходимо исключить актиномикоз и туберкулез.
Такие неспецифические симптомы лимфосарком, как лихорадка без очевидных причин, ночная потливость, потеря веса, астения в большинстве случаев указывают на генерализованный характер заболевания. Среди экстранодальных поражений доминируют неходжкинские лимфомы кольца Пирогова-Вальдейера, ЖКТ, головного мозга, реже поражаются молочная железа, кости, паренхима легких и др. органы. Лимфома носоглотки при эндоскопическом исследовании имеет вид опухоли бледно-розового цвета с бугристыми контурами. Часто прорастает верхнечелюстную и решетчатую пазуху, орбиту, вызывая затруднение носового дыхания, ринофонию, снижение слуха, экзофтальм.
Первичная лимфосаркома яичка может иметь гладкую или бугристую поверхность, эластическую или каменистую плотность. В некоторых случаях развивается отек мошонки, изъязвление кожи над опухолью, увеличение пахово-подвздошных лимфоузлов. Лимфомы яичка предрасположены к ранней диссеминации с поражением второго яичка, ЦНС и др.
Лимфома молочной железы при пальпации определяется как четкий опухолевый узел или диффузное уплотнение груди; втяжение соска нехарактерно. При поражении желудка клиническая картина напоминает рак желудка, сопровождаясь болями, тошнотой, потерей аппетита, снижением веса. Абдоминальные лимфосаркомы могут проявлять себя частичной или полной кишечной непроходимостью, перитонитом, синдромом мальабсорбции, болями в животе, асцитом. Лимфома кожи проявляется зудом, узелками и уплотнением красновато-багрового цвета. Первичное поражение ЦНС более характерно для больных СПИДом - течение лимфомы данной локализации сопровождаются очаговой или менингеальной симптоматикой.
Осложнения
Наличие значительной опухолевой массы может вызывать сдавление органов с развитием жизнеугрожащих состояний. При поражении медиастинальных лимфоузлов развивается компрессия пищевода и трахеи, синдром сдавления ВПВ. Увеличенные внутрибрюшные и забрюшинные лимфатические узлы могут вызвать явления кишечной непроходимости, лимфостаза в нижней половине туловища, механической желтухи, компрессии мочеточника. Прорастание стенок желудка или кишечника опасно возникновением кровотечения (в случае аррозии сосудов) или перитонита (при выходе содержимого в брюшную полость). Иммуносупрессия обусловливает подверженность пациентов инфекционным заболеваниям, представляющим угрозу для жизни. Для лимфом высокой степени злокачественности характерно раннее лимфогенное и гематогенное метастазирование в головной и спинной мозг, печень, кости.
Диагностика
Вопросы диагностики неходжкинских лимфом находятся в компетенции онкогематологов. Клиническими критериями лимфосаркомы служат увеличение одной или нескольких групп лимфоузлов, явления интоксикации, экстранодальные поражения. Для подтверждения предполагаемого диагноза необходимо проведение морфологической верификации опухоли и инструментальной диагностики:
- Исследование клеточного субстрата опухоли. Выполняются диагностические операции: пункционная или эксцизионная биопсия лимфоузлов, лапароскопия, торакоскопия, аспирационная пункция костного мозга с последующими иммуногистохимическими, цитологическими, цитогенетическими и другими исследованиями диагностического материала. Кроме диагностики, установление структуры НХЛ важно для выбора тактики лечения и определения прогноза.
- Методы визуализации. Увеличение медиастинальных и внутрибрюшных лимфоузлов обнаруживается с помощью УЗИ средостения, рентгенографии и КТ грудной клетки, брюшной полости. В алгоритм обследования по показаниям входят УЗИ лимфатических узлов, печени, селезенки, молочных желез, щитовидной железы, органов мошонки, гастроскопия. С целью стадирования опухоли проводится МРТ внутренних органов; в выявлении метастазов информативны лимфосцинтиграфия, сцинтиграфия костей.
- Лабораторная диагностика. Направлена на оценку факторов риска и функции внутренних органов при лимфомах различных локализаций. В группе риска производится определение ВИЧ-антигена, анти-HCV. Изменение периферической крови (лимфоцитоз) характерно для лейкемизации. Во всех случаях исследуется биохимический комплекс, включающий печеночные ферменты, ЛДГ, мочевую кислоту, креатинин и др. показатели. Своеобразным онкомаркером НХЛ может служить b2-микроглобулин.
Дифференцировать неходжкинские лимфомы приходится с лимфогранулематозом, метастатическим раком, лимфаденитами, возникающими при туляремии, бруцеллезе, сифилисе, туберкулезе, токсоплазмозе, инфекционном мононуклеозе, гриппе, СКВ и др. При лимфомах конкретных локализаций проводятся консультации профильных специалистов: оториноларинголога, гастроэнтеролога, маммолога и т.д.

Лечение
Варианты лечения неходжкинских лимфом включают оперативный метод, лучевую терапию и химиотерапию. Выбор методики определяется морфологическим типом, распространенностью, локализацией опухоли, сохранностью и возрастом больного. В современной онкогематологии приняты протоколы лечения лимфосарком, базирующиеся на использовании:
- Химиотерапии. Наиболее часто лечение лимфом начинают с курса полихимиотерапии. Этот метод может являться самостоятельным или сочетаться с лучевой терапией. Комбинированная химиолучевая терапия позволяет достичь более длительных ремиссий. Лечение продолжается до достижения полной ремиссии, после чего необходимо проведение еще 2-3 консолидирующих курсов. Возможно включение в циклы лечения гормонотерапии.
- Хирургических вмешательств. Обычно применяется при изолированном поражении какого-либо органа, чаще - ЖКТ. По возможности операции носят радикальный характер - выполняются расширенные и комбинированные резекции. В запущенных случаях, при угрозе перфорации полых органов, кровотечения, непроходимости кишечника могут выполняться циторедуктивные вмешательства. Хирургическое лечение обязательно дополняется химиотерапией.
- Лучевой терапии. В качестве монотерапии лимфом применяется только при локализованных формах и низкой степени злокачественности опухоли. Кроме этого, облучение может быть использовано и в качестве паллиативного метода при невозможности проведения других вариантов лечения.
- Дополнительных схем лечения. Из альтернативных методов хорошо себя зарекомендовала иммунохимиотерапия с применением интерферона, моноклональных антител. С целью консолидации ремиссии применяется трансплантация аутологичного или аллогенного костного мозга и введение периферических стволовых клеток.
Прогноз и профилактика
Прогноз при неходжкинских лимфомах различен, зависит, главным образом, от гистологического типа опухоли и стадии выявления. При местнораспространенных формах долгосрочная выживаемость в среднем составляет 50-60%, при генерализованных - всего 10-15%. Неблагоприятными прогностическими факторами служат возраст старше 60 лет, III-IV стадии онкопроцесса, вовлечение костного мозга, наличие нескольких экстранодальных очагов. Вместе с тем, современные протоколы ПХТ во многих случаях позволяют добиться долгосрочной ремиссии. Профилактика лимфом коррелирует с известными причинами: рекомендуется избегать инфицирования цитопатогенными вирусами, токсических воздействий, чрезмерной инсоляции. При наличии факторов риска необходимо проходить регулярное обследование.
2. Эпидемиология и биология неходжкинских лимфом/ Хансон К.П., Имянитов Е.Н.// Практическая онкология. - 2004 - Т.5, №3.
4. Современные подходы к терапии неходжкинских лимфом/ Поддубная И. В.// Русский медицинский журнал. - 2011. - №22.
Определение, эпидемиология и иммуноморфологическая характеристика лимфомы Ходжкина
Информация только для специалистов в сфере медицины, фармации и здравоохранения!

Глава первая карманных рекомендаций по лечению
лимфомы Ходжкина.
Специализированное издание,
предназначенное для медицинских и фармацевтических работников
Автор руководства: Демина Е.А. - д.м.н., профессор, профессор кафедры гематологии и клеточной терапии Института усовершенствования врачей ФГБУ«Национальный медико-хирургический центр им. Н.И. Пирогова» Минздрава России (заведующий кафедрой д.м.н., профессор В.Я. Мельниченко).
Лимфома Ходжкина (ЛХ) - это злокачественное опухолевое заболевание лимфатической системы. Впервые как самостоятельное заболевание, а не как сочетание отдельных признаков было описано в 1832 г. Томасом Ходжкиным (Thomas Hodgkin). Социальную значимость проблемы определяют молодой возраст (заболевают ЛХ преимущественно в возрасте 18-35 лет, т. е. в наиболее социально активном и репродуктивном возрасте) и возможность излечения большинства больных. ЛХ - первое онкологическое заболевание, которое было признано потенциально излечимым уже в середине прошлого века, а введение в лечебную практику комбинированного химиолучевого лечения и принципа «объем лечения должен соответствовать объему поражения» позволили к началу текущего столетия увеличить 5-летнюю общую выживаемость (ОВ) больных при любых стадиях заболевания до 90% и предоставить шанс на излечение 80-90% пациентов (рис. 1).
Рисунок 1. Выживаемость больных лимфомой Ходжкина по данным Германской группы по изучению лимфомы Ходжкина (German Hodgkin Study Group (GHSG)), протоколы HD9, HD8 и HD7

Определение
ЛХ - злокачественная опухоль, возникающая при нарушении нормального лимфопоэза В-лимфоцитов в герминальном центре лимфатического узла и распространяющаяся преимущественно путем лимфогенного метастазирования, на первых этапах - в близлежащие лимфатические коллекторы, а при генерализации процесса - в органы и ткани.
Название «лимфома Ходжкина» отражает патогенез заболевания и введено ВОЗ в 2001 г. (устаревшие названия: «лимфогранулематоз», «болезнь Ходжкина»).
В 4-м издании Классификации опухолей гемопоэтической и лимфоидной тканей ВОЗ 2017 г. в главе 15 рассматриваются два различных заболевания: классическая ЛХ (кЛХ), на долю которой приходится 95% всех случаев ЛХ, и нодулярная с лимфоидным преобладанием ЛХ (НЛПЛХ), которая составляет лишь 5%.
Эпидемиология
Классическая лимфома Ходжкина
Заболеваемость кЛХ в России в 2016 г. составила 2,13 на 100 тыс. населения в год (3129 впервые диагностированных больных), смертность - 0,6. Болеют ЛХ люди любого возраста. Пик заболеваемости кЛХ приходится на возраст 20-35 лет (рис. 2). Мужчины заболевают несколько чаще, чем женщины. Среди молодых больных преобладают женщины, а среди больных старших возрастных групп - мужчины. Заболеваемость ЛХ за несколько последних десятилетий почти не изменилась, а смертность снизилась с 2,7 до 0,6-0,7. Случаи кЛХ в одной семье редки - стандартизированный показатель частоты (standardized incidence ratios (SIRs)) у родственников первой степени составляет 5,3.
Рисунок 2. Заболеваемость лимфомой Ходжкина в России (адаптировано из [72])

Нодулярная лимфома Ходжкина с лимфоидным преобладанием
НЛХЛП не является вариантом кЛХ. Это самостоятельная редкая (заболеваемость - 1,5 на 1 млн) лимфома с иным, чем у кЛХ, патогенезом и иммунофенотипом (табл. 1), иной клинической картиной, отли чающейся индолентным течением. Болеют НЛХЛП в любом возрасте, но пик заболеваемости смещен на возрастной интервал 35-50 лет, среди заболевших преобладают мужчины, SIRs у родственников первой степени достигает 19 и наиболее высок у родственниц молодых пациентов.
Таблица 1. Морфологическая классификация лимфомы Ходжкина (ВОЗ, 2017)
- с нодулярным склерозом, типы I и II;
- смешанно-клеточный;
- богатый лимфоцитами;
- с лимфоидным истощением
Иммуноморфологическая характеристика
Опухолевым субстратом кЛХ является гигантская двух- или многоядерная клетка Березовского - Рид - Штернберга (Б-Р-Ш) (синонимы: клетка Березовского - Штернберга или Штернберга - Рид) (рис. 3а). Кроме того, к опухолевой популяции кЛХ относят также клетки Ходжкина, лакунарные, мумифицированные и LP-клетки.
Рисунок 3. Классическая лимфома Ходжкина
При гистологическом исследовании в опухолевом субстрате опухолевые клетки Б-Р-Ш располагаются одиночно среди выраженного реактивного микроокружения и составля-ют лишь около 10% всей опухолевой массы (рис. 3б). Основная масса опухоли представ-лена многочисленными и разнообразными неопухолевыми клетками микроокружения: Т-лимфоцитами, макрофагами, NK-клетками, эозинофильными и нейтрофильными гранулоцитами. Это разнообразное клеточное окружение отражает неэффективный иммунный ответ при кЛХ.
Морфологически при кЛХ выделяют 4 гистологических варианта, которые характеризуются единым иммунофенотипом (табл. 1). Особенностью опухолевых клеток Б-Р-Ш является потеря классического В-клеточного тиммунофенотипа. Клетки Б-Р-Ш экспрессируют CD30 и CD15, только в 20-40% случаев - CD20, не экспрессируют CD45 и BоB.1, PAX5 - слабая ядерная экспрессия, Oct-2 не экспрессируется или окрашивается в части клеток. При отсутствии экспрессии CD30 диагноз кЛХ сомнителен и требует расширенного иммуногистохимического исследования.
Вариант кЛХ с нодулярным склерозом преобладает у молодых больных в возрастном интервале 16-35 лет, а смешанно-клеточный - у детей и больных старшей возрастной группы. Варианты с лимфоидным истощением и с нодулярным склерозом II типа прогностически менее благоприятны, однако они встречаются редко - не более чем в 10% случаев.
В отличие от кЛХ опухолевые клетки при НЛХЛП одинаково интенсивно экспрессируют CD20, Pax5 и другие В-клеточные антигены, при этом CD30 и CD15 отсутствуют. Опухолевый субстрат при НЛХЛП представлен популяцией злокачественных клеток, классифицированных как LP (lymphocyte predominant, классификация ВОЗ 2008 г.). Ядра LP-клеток светлые с мелкодисперсным хроматином, часто многодольчатые и имеют вид «вздувшихся», что послужило поводом назвать LP-клетки «popcorn»-клетками - клетками типа «воздушной кукурузы» (рис. 4). Рисунок строения лимфатического узла стерт тотально или частично за счет многочисленных крупных нодулей, которые образованы мелкими лимфоидными клетками, более компактно расположенными по периферии нодулей (рис. 5а), что отличает НЛХЛП от варианта с нодулярным склерозом кЛХ, при котором нодули окружены коллагеновыми волокнами (рис. 5б). Так же как и клетки Б-Р-Ш при кЛХ, LP-клетки дискретно и довольно равномерно располагаются в пределах нодулей среди реактивного В-клеточного микроокружения и составляют около 1% всех клеток опухоли. НЛХЛП может содержать участки трансформации по типу В-клеточной крупноклеточной лимфомы, богатой Т-клетками / гистиоцитами (ТHRLBCL), которая может выявляться при любой стадии заболевания
Рисунок 4. Нодулярная лимфома Ходжкина с лимфоидным преобладанием

Рисунок 5. Нодулярная лимфома Ходжкина с лимфоидным преобладанием (а) и классическая лимфома Ходжкина, вариант с нодулярным склерозом (б)

Диагноз ЛХ устанавливается только при патологоанатомическом (гистологическом, иммуногистохимическом) исследовании по биопсированному лимфатическому узлу и считается доказанным только в том случае, если при гистологическом исследовании найдены опухолевые клетки (Б-Р-Ш, Ходжкина, лакунарные или близкие к ним). Иммуногистохимическое исследование для подтверждения диагноза ЛХ сегодня является обязательным, т. к. только оно позволяет решить вопрос о назначении адекватной терапии, в первую очередь иммунотерапии. При современных требованиях к верификации диагноза ЛХ COR-биопсия в большинстве случаев оказывается недостаточной, т. к. не позволяет изучить структуру лимфоузла и ограничивает возможности проведения иммунофенотипирования из-за малого количества биопсийного материала и его деформации. Цитологическое исследование является очень ценной диагностической процедурой, но не достаточной для выбора программы лечения.
Другие главы книги: Содержание:
По вопросам заказа книги обращайтесь в отдел подписки:
© Все права защищены. Никакая часть данной книги не может быть воспроизведена в какой бы то ни было форме без письменного разрешения владельцев авторских прав.
Лимфома Ходжкина
Лимфома Ходжкина (лимфогранулематоз) — это онкологическое заболевание, поражающее лимфоциты и разрушающее иммунную систему пациента. При своевременном начале лечения стойкой ремиссии удаётся добиться почти в 90% случаев.
Акции

Полное обследование на онкологические заболевания для мужчин и женщин.
Онкоконсилиум может потребоваться как при лечении в «СМ-Клиника», так и пациентам других медицинских учреждений с целью получения альтернативного мнения.
«СМ-Клиника» предоставляет своим пациентам предоперационное обследование со скидкой до 72%!
Консультация врача-хирурга по поводу операции бесплатно!
Содержание статьи:
Лимфомы - это группа злокачественных опухолей, поражающих лимфатическую систему, отвечающую в здоровом организме за иммунитет. Одним из первых и типичных признаков этих опухолевых патологий является безболезненное увеличение лимфатических узлов до 20 мм и более в разных частях тела.
Лимфомы, аналогично другим злокачественным образованиям, обладают способностью к метастазированию как с током крови либо лимфы, так и прорастая контактным путем в неповрежденные ткани, где затем размножаются раковые клетки. Диагноз любого вида лимфомы устанавливается только по результатам морфологического исследования ткани, взятой из опухоли в ходе биопсии.
Лимфома Ходжкина: что это за болезнь
Это злокачественное заболевание получило свое название по имени первооткрывателя. Впервые Томас Ходжкин описал эту лимфому еще в 1832 году. Сегодня в научном мире ее называют лимфогранулематозом - это процесс злокачественной гиперплазии (разрастания) лимфоидной ткани. Ключевым признаком патологии считают образование гранулем, в которых находят клетки Березовского-Штернберга.
При лимфогранулематозе увеличиваются пакеты лимфоузлов в разных частях тела: чаще страдают надключичные группы, нижнечелюстные узлы или медиастенальные. Также типично увеличение в объеме селезенки, постоянное повышение температуры, зуд кожи, потеря веса и выраженная слабость.
На сегодня лимфома Ходжкина - одно из наиболее изученных злокачественных новообразований. С 70-х годов прошлого века она утратила статус неизлечимой патологии. Если лечение начато своевременно, выживает до 98% пациентов, рецидивирует опухоль крайне редко.
По данным общемировой статистики ходжкинская лимфома возникает с частотой 2,2 на 100 тысяч населения. Обычно болеют молодые люди в возрасте до 30 лет или лица старше 60 лет. Мужчины почти в два раза чаще, нежели женщины. После лейкемии лимфогранулематоз занимает второе место по встречаемости.
Причины развития Лимфомы Ходжкина
Аргументы, которые приводятся в пользу вирусного происхождения лимфомы - при ней часто выявляется ранее перенесенный мононуклеоз (в крови есть антитела к вирусу Эпштейна-Барр и около 20% клеток Березовского-Штернберга также содержат частицы вируса). Также рассматривается влияние ретровирусов, включая ВИЧ.
В пользу наследственной теории говорит тот факт, что выявлены семейные случаи лимфомы Ходжкина с выявление определенных генетических маркеров.
По данным иммунологической теории считается, что при переносе материнских лимфоцитов через плаценту к плоду, у него развиваются реакции иммунопатологического типа.
Возможно влияние внешних мутагенов - токсинов, излучений, препаратов в патогенезе этой формы лимфомы.
Считается, что лимфогранулематоз возникает при дефиците Т-клеточного иммунитета, так как при ее развитии страдают клетки и меняется соотношение Т-клеток хелперов с супрессорами. Ключевыми признаками, точно определяющими болезнь, считаются клетки Березовского-Штернберга или их предшественники - клетки Ходжкина в сочетании с поликлональными лимфоцитами, эозинофилами и плазматическими клетками.
Изначально опухоль имеет один очаг в лимфоузлах, но затем метастазирует, формируя поражения легких, пищеварения, костного мозга или почек.
Классификация лимфомы Ходжкина
Гематологами различаются различные типы лимфомы:
- локальная (либо изолированная) - поражается только одна группа лимфоузлов;
- генерализованная - злокачественное прорастание в ткани (печень, селезенка, кожа, желудок, легкие).
По локализации можно соответственно выделить несколько форм лимфогранулематоза:
- периферический;
- легочный;
- медиастенальный;
- костный;
- кожный;
- абдоминальный;
- желудочно-кишечный;
- нервный вариант патологии.
По скорости развития патологии лимфома Ходжкина может иметь острое течение (развивается всего за несколько месяцев до терминального состояния), либо хроническое (с затяжным развитием симптомов, чередованием обострений с периодами ремиссии).
Также в современных клинических рекомендациях выделяют 4 основных гистологических формы болезни, которые определяют по данным биопсии и подсчета соотношения клеток. Это:
- преобладание лимфоцитов (или лимфогистиоцитарная стадия);
- нодулярный склероз;
- смешанноклеточная;
- истощение лимфоцитов.
Стадирование лимфомы Ходжкина
По клинической классификации, в основе которой лежит распространенность опухоли, можно делать прогноз относительно эффективности лечения. Согласно этой классификации лимфогранулематоз делят на четыре стадии:
- Стадия I или локальная: поражение расположено только в одной группе лимфоузлов или поражает один орган.
- Стадия II или регионарная: поражаются две группы лимфоузлов или больше, либо страдает один орган с прилегающими к нему лимфоузлами.
- Стадия III или генерализованная: лимфоузлы поражены с обеих сторон от области диафрагмы. Также поражается один из органов, ткань селезенки.
- Стадия IV или диссеминированная: поражения расположены в нескольких органах и одновременно страдают их лимфоузлы.
Если имеются общие симптомы лимфомы в течение последнего полугода (потеря веса, лихорадка, потливость), к стадии добавляют букву А, если нет - В.
Одним из типичных симптомов считается увеличение в размерах лимфоузлов, которые расположены под кожей и доступны для прощупывания. Чаще всего увеличиваются лимфоузлы в области подмышек, паха, бедренные. Сами лимфоузлы плотные по консистенции, они подвижны, не болят, не спаяны друг с другом, с кожными покровами и тканями, имеют вид цепочек.
Примерно у пятой части пациентов изначально увеличиваются лимфоузлы в грудной клетке (медиастенальные). Тогда может возникать нарушение глотания, одышка, сухой кашель. При поражении узлов в забрюшинном пространстве или мезентериальных, будет боль в животе, отек ног.
У четверти пациентов страдает легочная ткань. Могут возникать явления пневмонии, образуются полости, а при захвате плевры - признаки плеврита с экссудацией (скопление жидкости в полости плевры).
Если поражаются кости, чаще всего страдает грудина, позвоночник, ребра или тазовые кости, реже вовлекаются черепа и трубчатые кости. Возникают боль в костях, изменения позвонков. Поражение костного мозга ведет к понижению тромбоцитов, анемии и лейкопении.
Лимфома в области пищеварительной системы ведет к повреждению мышечного слоя кишки, образованию язвенных дефектов слизистой с кровотечениями. Это может приводить к образованию отверстий в стенке кишки и перитониту. Если поражается печень, повышается уровень ферментов, увеличивается размер органа. Если вовлекается спинной мозг, возможны параличи. При терминальной стадии возможны поражения кожи, груди, яичников или яичек, сердца, матки, щитовидной железы, глаз.
Диагностика лимфомы Ходжкина
При наличии типичных признаков - увеличенных лимфоузлов, печени с селезенкой, похудением, лихорадкой, необходимо проведение полного обследования. Основу постановки диагноза составляет исследование биопсийного материала - забора материала из лимфоузлов, выполнение торако-, лапароскопии с забором образцов.
Диагноз подтверждается обнаружением типичных изменений и клеток Березовского. Если выявлены клетки Ходжкина, это может стать предположением лимфомы, но не дает повода для начала лечения.
При лимфоме Ходжкина необходимо исследование анализа крови, биохимии, чтобы оценить работу костного мозга и печени. Они не подтверждают диагноз, но могут определить отклонения в работе внутренних органов. В общем анализе определяются:
- сниженный уровень гемоглобина;
- понижение количества тромбоцитов;
- увеличен уровень лейкоцитов за счет моноцитоза, эозино-и базофилии;
- количество лимфоцитов легко снижено;
- СОЭ ускорено до 20-25 мм/ч и выше.
В биохимическом анализе отмечает повышение воспалительных маркеров, в том числе количества СРБ, фибриногена, альфа-два-глобулина. В поздней стадии повышаются уровни билирубина и АЛТ, АСТ.
Также показано выполнение стернальной пункции (при подозрении на поражение костного мозга), выполнение рентгенографии груди, КТ брюшной полости, средостения, сцинтиграфии костей, лимфографии.
Методы лечения лимфомы Ходжкина
Современные методы лечения этой болезни позволяют добиться стойкой ремиссии. Терапия проводится поэтапно, с учетом стадии лимфогранулематоза. Применяют комбинацию лучевой терапии, циклы полихимиотерапии, таргетную терапию.
При стадиях I-IIА применяется только лучевая терапия, позволяющая устранить опухолевые клетки в области единичных пораженных узлов или органа. Также предварительно пораженные узлы и селезенку удаляют. Облучают как пораженные узлы, так и неизмененные, для профилактики рецидивов.
При стадии IIВ - IIIА применяют комбинацию лучевого лечения и химиотерапии. Сначала делают вводную полихимиотерапию, затем облучают только пораженные лимфоузлы, после этого - остальные узлы и применяют поддерживающую химиотерапию в течение 2-3 лет.
В стадии IIIВ - IV показаны циклы полихимиотерапии, а в стадии ремиссии циклы облучения или медикаментов. Все лечение проводится согласно специальным онкологическим протоколам.
Современные разработке в онкологии позволили сегодня применять в лечении лимфомы Ходжкина таргетную терапию. Это соединения, которые блокируют у опухоли ключевые молекулы, отвечающие за ее размножение, рост и сопротивление иммунной системе. Таргетные препараты более избирательны в сравнении с обычно химиотерапией, они влияют только на раковые клетки, не трогая собственные. Применяют несколько вариантов препаратов:
- ингибиторы протеасом;
- блокаторы гистондеацетилазы;
- блокаторы киназ;
- другие препараты.
Препараты вводят курсами с последующей оценкой изменений по данным обледований.
После лечения возможны определенные результаты:
- Наступление полной ремиссии - в течение месяца исчезают все признаки болезни (субъективные и объективные);
- Наступление частичной ремиссии - устраняются признаки болезни, уменьшаются лимфоузлы и очаги вне узлов на 50% и более.
Также возможно клиническое улучшение, отсутствие динамики, тогда курс лечения корректируют.
Врачи в ходе лечения делают все возможное, чтобы предотвратить возможные осложнения.
Прогноз при лимфоме Ходжкина
В стадии 1-2 пятилетняя выживаемость достигает 90% и более. При выявлении лимфомы на стадии III A выживаемость в течение пяти лет и шансы на безрецидивную жизнь составляют по оценкам экспертов примерно 80%. Если это стадия лимфомы III Б стадии — шансы на безрецидивное течение и выживание на протяжении пятилетия снижаются до 60%. На IV стадии после проведения полного курса терапии - полихимиотерапии в сочетании с облечением, процент выживания снижается до 45%.
Среди неблагоприятных признаков можно выделить острый лимфогранулематоз, образование участков пораженных лимфоузлов более 5 см, поражение большого объема узлов и органов, селезенки и печени.
Рецидивы бывают редко, обычно они возникают из-за нарушения циклов поддерживающего лечения, после беременности или тяжелых нагрузок. Пациентам нужно постоянно находиться на учете у онколога.
Профилактика
Эффективных вариантов профилактики при развитии лимфомы на сегодняшний день не разработано. Это связано с тем, что не определены точные причинные факторы, которые провоцируют развитие опухоли.
Михайлов Алексей Геннадьевич оперирующий онколог, врач высшей квалификационной категории, к.м.н. стаж: 21 год
Информация в статье предоставлена в справочных целях и не заменяет консультации квалифицированного специалиста. Не занимайтесь самолечением! При первых признаках заболевания необходимо обратиться к врачу.
Неходжкинская лимфома
Неходжкинские лимфомы - системные злокачественные опухоли иммунной системы из клеток внекостномозговой лимфоидной ткани. НХЛ может возникать у людей всех возрастов, однако более половины разновидностей заболевания диагностируют у пациентов старше 60 лет.
Неходжкинские лимфомы (НХЛ) - это опухолевые заболевания лимфы, которые представлены злокачественными B- и T-клеточными лимфомами. По мере прогрессирования опухоль может давать метастазы по всему организму, распространяясь гематогенным путем или через лимфу.
Основными симптомами неходжкинских лимфом костного мозга являются увеличение лимфоузлов, признаки поражения тех или иных органов, повышение температуры тела, интоксикация организма. Диагноз ставится на основе клинической картины, данных рентгенографии, результатов анализов крови, биологического материала, взятого из костного мозга и лимфоузлов. Лечение комплексное, включает в себя лучевую и химиотерапию.
Лимфома неходжкинского типа может возникать у людей всех возрастов, однако более половины разновидностей заболевания диагностируют у пациентов старше 60 лет. В последние годы прослеживается четкая тенденция к увеличению заболеваемости данным видом онкологии.
Причины неходжкинских лимфом
Точные причины возникновения неходжкинской лимфомы (рака) неизвестны, хотя многие данные указывают на вирусную этиологию заболевания. Риск возникновения опухоли также повышают некоторые бактерии (например, Helicobacter pylori).
К факторам, которые увеличивают риск развития заболевания, также относят:
- иммунодефицит (первичный или вторичный, который может быть вызван приемом иммунодепрессантов);
- увеличение и хроническое воспаление лимфоузлов;
- воздействие химикатов (инсектицидов, гербицидов);
- наследственная предрасположенность — повышенный риск у людей, близкие родственники которых имеют диагноз неходжкинская лимфома или лимфома Ходжкина.
Неходжкинская лимфома неуточненного типа является второй по частоте опухолью у пациентов с ВИЧ. Что касается патогенеза неходжкинских лимфом, то большая их часть (около 85%) происходит из В-лимфоцитов (неходжкинская В-клеточная лимфома). Новообразование может развиваться как из клеток-предшественниц, так и из зрелых клеток. Стадия дифференцирования лимфоцитов определяет клинику и исход патологии.
Симптомы НХЛ
Клинические проявления общих симптомов и признаков неходжкинских лимфом могут быть самыми разными.
Первые признаки неходжкинской лимфомы:
- потливость в ночное время;
- повышенная утомляемость, слабость, снижение работоспособности;
- кожный зуд неясной этиологии;
- резкая беспричинная потеря веса;
- повышение температуры тела, не связанное с инфекционными заболеваниями.
Почти половина новообразований возникает в лимфоузлах. В результате они увеличиваются в размере, при пальпации лимфоузлы безболезненные, плотные с окружающими тканями не спаяны, часто сливаются в конгломераты.
Если опухоль возникает в глоточном конце, то у пациента нарушается дыхание, возникает заложенность носа, ощущение инородного тела во время глотания. Миндалины увеличены, возможно свисание синюшной бугристой опухоли из области носоглотки. В патологический процесс могут вовлекаться слюнные железы, пазухи, носовая полость, глазные орбиты, основание черепа. Довольно часто у пациентов увеличены подчелюстные и шейные лимфатические узлы.
Новообразования, возникающие в вилочковой железе и внутригрудных лимфоузлах вначале не имеют выраженной клинической картины.
По мере прогрессирования онкологического заболевания возникают следующие симптомы:
- синюшность кожи в области шеи и лица;
- нарушение глотания;
- одутловатость лица;
- осиплость либо потеря голоса;
- боли в области сердца;
- сухой, мучительный кашель, одышка, боль в груди.
Если опухоль развивается в брюшной полости, то вначале болезнь протекает бессимптомно. По мере роста новообразования появляются несильные боли в животе, метеоризм, вздутие, тошнота. При отсутствии лечения симптомы усиливаются, боли в животе становятся сильными, брюшная стенка напряжена, появляется рвота, возможно развитие кишечной непроходимости.
Если лимфома поражает кожу, то клинически это проявляется образованием узелков, папул, шелушащихся бляшек, могут появляться язвы, зуд. Высыпания могут иметь различный цвет (от багрового до ярко-розового). Увеличиваются лимфоузлы.
При любом типе опухоли может наблюдаться поражение ЦНС. В этом случае к основной клинической картине присоединяется головная боль, нарушение зрения, слуха, параличи, парезы. При поражении костного мозга количество клеток крови в организме уменьшается.
Классификация неходжкинских лимфом
Основные виды неходжкинских лимфом:
- В-клеточные:
- диффузная неходжкинская В-крупноклеточная лимфома;
- мелкоклеточная неходжкинская лимфома;
- нодальная лимфома маргинальной зоны;
- фолликулярная неходжкинская лимфома;
- экстранодальные лимфомы маргинальной зоны;
- селезеночная лимфома маргинальной зоны;
- первичная лимфома ЦНС;
- первичная медиастинальная лимфома;
- лимфоплазмоцитарная лимфома;
- лимфома Беркитта.
- Т-лимфобластная лимфома из клеток-предшественников;
- периферические Т-клеточные лимфомы.
Стадии неходжкинских лимфом
В зависимости от локализации новообразования и количества пораженных органов выделяют четыре стадии заболевания:
1 стадия Поражено не более одной группы лимфоузлов. 2 стадия Поражено две и более групп лимфоузлов с одной стороны от диафрагмы. 3 стадия Поражено две и более групп лимфатических узлов с обеих сторон диафрагмы либо поражены лимфоузлы над диафрагмой и селезенка. 4 стадия Поражаются ткани по всему организму с вовлечением в патологический процесс лимфоузлов (в зависимости от пораженного органа), костного мозга, центральной нервной системы. Диагностика лимфом неходжкинского типа
Заподозрить данную патологию можно при одновременном безболезненном увеличении сразу нескольких групп лимфоузлов и наличии неспецифических общих клинических признаков со стороны пораженных органов.
Основным методом диагностики заболевания является биопсия с последующим цитогенетическим, цитологическим, иммуногистохимическим исследованием взятого биоматериала. Для подбора правильной терапии жизненно важно точно определить тип новообразования. Это улучшает прогноз и повышает шансы на достижение стойкой ремиссии.
Увеличение размеров внутренних и периферических лимфоузлов определяют с помощью визуализационных методов диагностики. Вначале показано проведение УЗИ. Затем, для уточнения диагноза, а также выявления метастазов неходжкинских лимфом и определения стадии болезни проводят сцинтиграфию костной ткани и МРТ внутренних органов. В ряде случаев показано проведение эндоскопии.
Лабораторная диагностика включает общие анализы крови при неходжкинских лимфомах, скрининг на инфекции для выявления факторов риска, а также биохимический анализ крови для оценки работы внутренних органов.
Методы лечения неходжкинских лимфом
Лечение различных форм неходжкинской лимфомы проводится только в условиях стационара, так как требует постоянного наблюдения за пациентом, использования высокотехнологичного оборудования, участия в процессе специалистов разного профиля.
Выбор методов терапии осуществляет лечащий врач, индивидуально для каждого пациента, в зависимости от типа опухоли, ее размеров, локализации, стадии рака, возраста больного, индивидуальных особенностей организма.
Основные методы лечения данного типа опухолей:
- . Используются препараты-цитостатики, которые подавляют распространение и рост клеток новообразования. Данный метод является основным при лечении большинства видов неходжкинских лимфом.
- Лучевая терапия. При данной патологии используется только в случае, если химиотерапия не дает нужного результата. . Инновационный метод лечения, суть которого заключается в прицельном воздействии только на клетки опухоли, без вовлечения здоровых лимфоидных тканей.
Прогноз выживаемости при неходжкинских лимфомах
Прогноз зависит от гистологического типа новообразования, степени, на которой опухоль была диагностирована, возраста пациента, наличия сопутствующих заболеваний. При местных формах процент пятилетней выживаемости составляет 50-60%, при генерализованных — 10-15%.
Неблагоприятный прогноз при неходжкинской лимфоме 4 стадии, вовлечении в патологический процесс костного мозга, наличии нескольких очагов поражения. Вместе с тем, современные протоколы лечения при своевременной диагностике позволяют в большинстве случаев добиться долгосрочной ремиссии.
Специфической профилактики не существует. Чтобы снизить риск развития заболевания необходимо соблюдать следующие рекомендации:
- отказаться от вредных привычек;
- соблюдать режим труда и отдыха;
- отказаться от малоподвижного образа жизни, чаще гулять на свежем воздухе;
- при работе на вредном производстве соблюдать все правила техники безопасности;
- по возможности избегать стрессов и нервного перенапряжения;
- укреплять иммунные механизмы защиты организма;
- заниматься физкультурой;
- правильно питаться.
Для своевременного выявления заболеваний лимфатической системы и крови необходимо ежегодно проходить профилактические обследования.
Читайте также:
